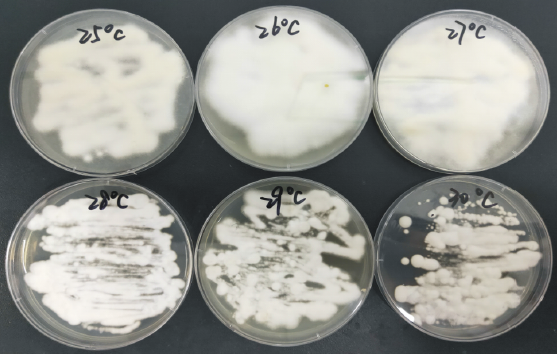

蛹虫草复合诱变育种与温度驯化研究
来源: 作者: 发布时间:2020-09-17 15:45 浏览量:36
本期为您推荐南京高新工大生物技术研究院有限公司,泸州品创科技有限公司,南京工业大学陈勇教授研究团队发表在《江西农业学报》上的一篇文章:蛹虫草复合诱变育种与温度驯化研究。
文章摘要内容如下:
虫草素是第一个从真菌中分离出来的核苷类抗生素,具有许多生物学活性。蛹虫草是生物法制备虫草素重要的菌株之一,传统的人工子实体固态培养法制备虫草素由于发酵工艺规模性体量大,耗时耗力,导致单位空间产量较低。液体发酵法生产虫草素最为关键的因素是菌株活性。但是,由于蛹虫草发酵温度较低,能耗较大,发酵周期较长,虫草素产率不理想,严重制约了其大规模生产。
目前蛹虫草诱变方法研究较多,如用化学诱变剂进行的化学诱变,用γ射线,离子束,UV等进行的物理诱变,也有不少同时用化学诱变和物理诱变进行的复合诱变。但鲜见有关高通量筛选和复合诱变技术相结合选育虫草素高产菌株的报道。
本研究为提高虫草素的发酵产量,以蛹虫草CICC14014为初始菌株,采用紫外(UV)照射与常压室温等离子体ARTP辐射相结合进行复合诱变,同时利用多孔板高通量筛选法实现虫草素高产突变菌株的快速筛选。结果表明,高产突变菌株在液体浅层静置培养条件下虫草素产量可达5.98g/L,比初始菌株(2.43 g/L)提高了146.1%。经过10次传代后菌株活性依然保持较高的水平。同时对诱变后菌株进行了温度驯化,经过10 轮温度梯度驯化,可耐28℃,最终产量可达6.56g/L。
文章精彩内容如下:

图2 UV-ARTP复合诱变致死曲线

图4 突变株UA40-6的遗传稳定性
图5 不同培养温度对菌体生长的影响

图6 不同发酵温度对虫草素产量影响
